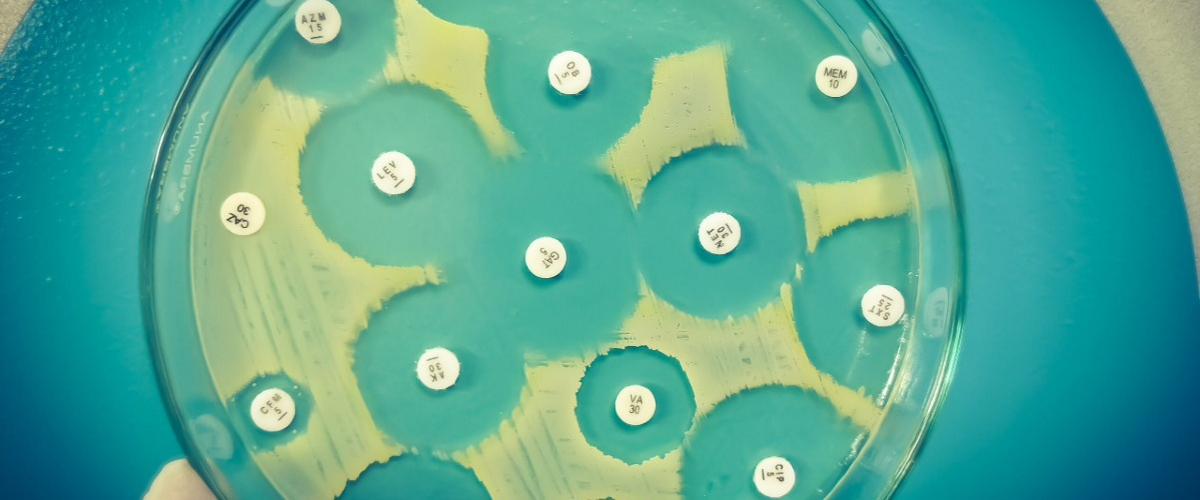
TODO:

Ученые из Университета Хоккайдо работали над созданием аналогов антибиактериальных препаратов под названием сферимицины. Эти соединения блокируют белок MraY, необходимый для репликации бактерий, а также для функции бактериальной клеточной стенки. В настоящее время MraY не является мишенью для существующих антибиотиков, поэтому ученые решили исследовать потенциальную возможность.
«Сферимицины являются сложными биологическими соединениями и имеют сложную структуру. Разработка аналогов может сделать их проще для производства и эффективнее против резистентных бактерий», — объяснил автор работы Сатоши Итикава.
Сначала было создано два аналога — SPM1 и SPM2. Первый был более эффективен, поэтому ученые решили усовершенствовать его и создали более простой SPM3 с аналогичными свойствами активности против патогенов.
Финальный препарат оказался эффективен для подавления устойчивого к метициллину золотистого стафилококка, устойчивого к ванкомицину энтерококка фэциум, а также возбудителя туберкулеза Mycobacterium tuberculosis, штаммы которого обладают множественной лекарственной устойчивостью.
«Созданный скелет сферимицина можно использовать для разработки большого количества антибактериальных агентов, нацеленных на MraY», — уточнил Итикава. Это означает, что появляется возможность создавать препараты по заданным свойствам, чтобы противостоять различным резистентным штаммам бактерий. Известно, что MraY также присутствует и у граммотрицательных бактерий, поэтому потенциал препарата велик.
Сегодня проблема резистентности бактерий к антибиотикам действительно носит глобальный характер — по оценке экспертов, от нее к 2050 году ежегодно будут умирать около 10 млн человек. Проблему осложняет и тот факт, что эти прогнозы не учитывают данных актуальных исследований. Например, недавно ученые идентифицировали новую форму устойчивости бактерий, которую нельзя определить даже по анализам.